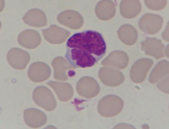

What is the investigation of choice in Strongy?
Baermann method
What is this?

Whipworm
What is the other name for whipworm?
Trichuris Trichiuria
Which of the nematodes is not a geohelminth?
Enterobius vermicularis
When do you not get eosinophilia in strongy?
may be absent if HTLV-1, corticosteroid tx: severe disease
Which is the only nematode to ovivivoparous?
Strongyloides stercoralis
Adult gives birth to larvae and eggs
Do you classically get eosinophilia with pinworm?
No
How do you diagnose enterobius vermicularis?
Sticky spatula perianally (Scotch tape)
Which of the nematodes is most commonly in the colon?
Trichuris trichiuria
Enterobius vermicularis
Both in caecum
How big is a pin worm?
1cm
What is the nematode associated with this?
Strongyloides
Flower cell
Which of the nematodes has a larvae as its infective stage?
Hookworm
Strongy
What is this?

Ascaris lumbricoides
What is the most common helminth in the world?
Ascaris lumbricoides
What is this?

Pinworm
What must you always rule out before Rx with strongy?
Loa Loa high parasite count
What nematode causes bowel obstruction, biliary duct obstruction, pancreatic duct obstruction.
Ascaris
Diagnostic stage for strongy?
Rhabditiform larvae in stool
What would you see on a stool sample of enterobius vermicularis?
Nothing!
Need to get eggs from skin perianally
Migrate at night time and hang around at terminal ileum during day so don’t catch them on stool sample
What do you use to Rx nematodes generally?
Albendazole
Except trichurius trichura - mebendazole
Which of the nematodes causes iron def anaemia?
Hookworm
Which of the nematodes causes appendicitis?
Trichuris trichiuria
How do you treat strongy?
2 doses orally
Infective stage of strongyloides stercoralis?
L3 filariaform larvae




















